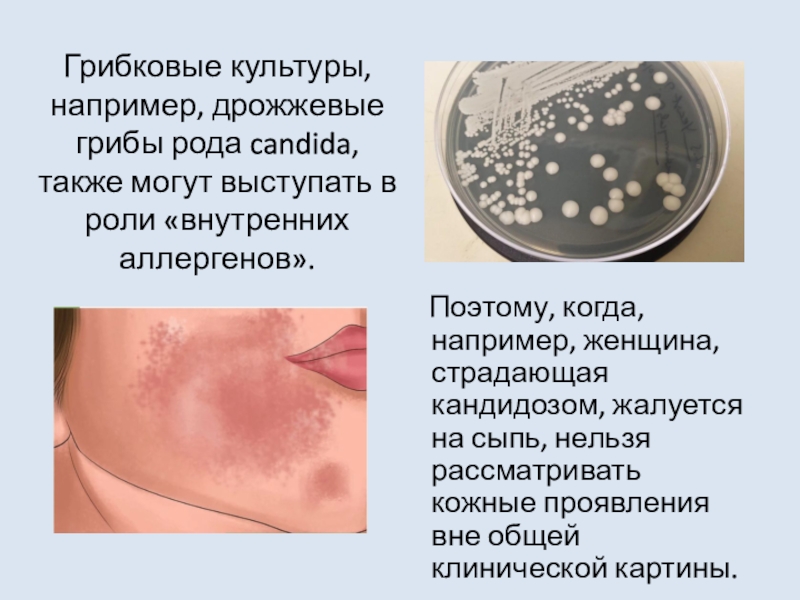

Разделы презентаций
- Разное
- Английский язык
- Астрономия
- Алгебра
- Биология
- География
- Геометрия
- Детские презентации
- Информатика
- История
- Литература
- Математика
- Медицина
- Менеджмент
- Музыка
- МХК
- Немецкий язык
- ОБЖ
- Обществознание
- Окружающий мир
- Педагогика
- Русский язык
- Технология
- Физика
- Философия
- Химия
- Шаблоны, картинки для презентаций
- Экология
- Экономика
- Юриспруденция
Фунготерапия при локальных воспалениях кожи. Угревая сыпь
Содержание
- 1. Фунготерапия при локальных воспалениях кожи. Угревая сыпь
- 2. Наружный покров телаКо́жа (cutis) — наружный покров тела человека.
- 3. Кожа Кожа является самым большим по
- 4. Функции кожи ЗАЩИТНАЯ Защищает организм
- 5. Функции кожиРЕЦЕПТОРНАЯ - благодаря наличию многочисленных нервных окончаний.
- 6. Слайд 6
- 7. Функции кожи ТЕРМОРЕГУЛЯТОРНАЯ – за счет излучения тепла и испарения пота.
- 8. Слайд 8
- 9. Функции кожиУчастие в ВОДНО – СОЛЕВОМ обмене (связано с потоотделением).
- 10. Функции кожи ЭКСКРЕТОРНАЯ - выведение с потом продуктов обмена, солей, лекарств.
- 11. Функции кожиКожа является периферическим звеном метаболизма мужских
- 12. Функции кожи МЕТАБОЛИЧЕСКАЯ – синтез и накопление витамина D
- 13. Функции кожи ИММУННАЯ - захват, процессинг и транспорт антигенов с последующим развитием иммунной реакции.
- 14. Особенности строения кожи и большое число внешних
- 15. Многие кожные заболевания — результат воздействия биологических факторов: микроскопических грибков, паразитов, вирусов.
- 16. У многих пациентов с кожными болезнями и
- 17. Грибковые культуры, например, дрожжевые грибы рода candida,
- 18. Аллергия и кожные заболевания – это не
- 19. Причины всех кожных заболеваний кроются в нарушении
- 20. Когда эти дренажные органы организма не справляются, токсины выводятся через кожу.
- 21. Дисбиоз кишечника – один из важнейших факторов,
- 22. Микрофлора кишечника — микроорганизмы, которые живут в ЖКТ в симбиозе с носителем.
- 23. Чудесный симбиоз человека и его микрофлорыМикробиота кишечника
- 24. Стрессы справедливо считаются причиной многих заболеваний и
- 25. Угревая болезнь (АКНЕ)
- 26. Ассоциируется с подростковым возрастомТрадиционно акне ассоциируется с
- 27. Подросток = тинейджер = 13-19 летПод воздействием
- 28. В индустриально-развитых странах от 79 до 95% тинейджеров испытывают на себе все «прелести» акне.
- 29. Заболеваемость в РоссииЗаболеваемость среди подростков в России
- 30. Пик заболеванияПик заболевания приходится на: 14-17 лет у девушек 16-18 лет у юношей
- 31. Акне вызывает у пациентов психо - эмоциональные
- 32. Подростковое акнеУ 80% пациентов акне самопроизвольно разрешаются к 18-20 годам, особенно у лиц мужского пола.
- 33. Тяжесть течения у подростков 39% - легкая степень 49% - средне-тяжелая 12% - тяжелая
- 34. АкнеВо всем мире пациентов с акне не просто стало больше, а увеличилось количество трудноизлечимых форм.
- 35. Справочная информация
- 36. Чем «питаются» современные молодые люди?
- 37. Полезные микроорганизмы кишечника Для питания необходимы
- 38. Нарушения в питании подростковДефицит животных белковДефицит ПНЖКДефицит
- 39. «Эпидемия» акне у взрослыхОднако теперь, в наши
- 40. СтатистикаСтойкие (персистирующие) акне, которые наблюдаются примерно у
- 41. Старше 25, 41-50 летОколо 54% женщин и
- 42. Слайд 42
- 43. Не подростковая проблема… Корни угревой
- 44. Акне (аcne vulgaris) – хроническое воспалительное заболевание,
- 45. ПАТОГЕНЕЗ АКНЕ Генетически обусловленный избыток андрогенов/повышенная чувствительность к
- 46. Причины повышения андрогенов в женском организмеВ период
- 47. Слайд 47
- 48. Строение кожи Кожа состоит
- 49. Кератиноциты Кератиноциты - основной тип клеток (85 %) эпидермиса. Кератиноциты проходят
- 50. КератинизацияКератинизация – это последовательный, послойный процесс в
- 51. Линолевая кислота является:1) Основным регулятором дифференцировки кератиноцитов. 2)
- 52. С учетом клинической картины заболевания выделяют:
- 53. Слайд 53
- 54. Патогенез развития Акне КератиноцитыУсиление процесса
- 55. Cutibacterium acneявляется представителем нормальной микрофлоры, патогенные свойства C. аcne не проявляются у здоровых людей.
- 56. Плотность колонизации Cutibacterium acnes увеличивается в себорейных
- 57. Избыточная бактериальная колонизация С.acne играет роль в поддержании патологического процесса.
- 58. С.acne стимулируют продукцию IL-1b кератиноцитами и макрофагами
- 59. Тенденция «взросления» заболевания в настоящее время, его
- 60. Новая концепция патогенеза акне В результате
- 61. При этом повышение маркеров воспаления происходит как
- 62. Эти находки позволили сделать предположение, что так
- 63. Научные исследования позволили выявить факторы, предрасполагающие к
- 64. Генетические особенности Врожденная гиперплазия надпочечников (дефицит
- 65. Ученые дали рекомендации дерматологам Информировать
- 66. Слайд 66
- 67. Причина акне - рацион питания«…Существуют убедительные доказательства
- 68. В антибиотиках нет необходимости, потому что составление
- 69. Наш организм «предпочитает» сложные углеводы, содержащиеся в
- 70. Растительные углеводы медленно распадаются на отдельные молекулы
- 71. Повышенный уровень ИФР-1 может привести к увеличению
- 72. ИФР - 1ИФР-1 также вызывает размножение клеток
- 73. В опубликованном в American Journal of Clinical Nutrition
- 74. Отказ от зерновых, сахара (особенно фруктозы), круп,
- 75. Слайд 75
- 76. Мнение специалиста китайской традиционной медицины о причине
- 77. В настоящее время также известно, что ключевую
- 78. При себорее захватывается кожа головы, лица, заушных
- 79. СебореяРазличают:сухую, жирную, густую, жидкую смешанную себорею: -
- 80. Лекарственные грибы, которые подавляют развитие Pityrosporum orbiculare в организме Мухомор Веселка Трутовик лиственничныйДождевикКордицепс
- 81. Базовая фунготерапия при кожных заболеваниях
- 82. Базовая фунготерапия при кожных заболеваниях
- 83. Базовая фунготерапия при кожных заболеваниях 3
- 84. Фунготерапия при угревой болезниДополнительно к базовой терапии Мейтакенормализация гормонального фона,улучшение функции печениуменьшение инсулинорезистентностинормализация углеводного обмена
- 85. Маски Для качественного косметического ухода за кожей лица – маски из гриба Весёлки и Мейтаке.
- 86. Маска Веселка Маска, омолаживающая для
- 87. Маска Мейтаке Маска, омолаживающая
- 88. Противовоспалительный эффект Ежедневное использование кремов Шиитаке
- 89. Пчелиная огневка Крем из пчелиной огневки
- 90. Тоник Использование тоника из концентрата серебряной
- 91. Крем РейшиПринимает активное участие в лечении акне
- 92. Грибная косметика от Ирины Филиповой
- 93. Спасибо за внимание!
- 94. Скачать презентанцию
Слайды и текст этой презентации
Слайд 1Фунготерапия при локальных воспалениях кожи. Угревая сыпь.
Центр Фунготерапии Ирины Филипповой
Фунготерапевт
Волкова Е.Н.
Слайд 3Кожа
Кожа является самым большим по площади органом. Площадь
кожи у взрослого человека достигает 1,5—2,3 м², масса 4-6 %, от
общей массы тела.Слайд 4Функции кожи
ЗАЩИТНАЯ
Защищает организм от действия
механических и химических факторов, ультрафиолетового излучения, проникновения микробов, потери и
попадания извне воды.Слайд 11Функции кожи
Кожа является периферическим звеном метаболизма мужских половых гормонов.
Стимуляция АР
повышает скорость деления клеток эпидермиса, стимулирует рост волос и секрецию
кожного сала.ЭНДОКРИННАЯ
Специфические андрогенные рецепторы расположены в сосочковом слое дермы, кератиноцитах, фибробластах, волосяных фолликулах, себоцитах.
Слайд 13Функции кожи
ИММУННАЯ - захват, процессинг и транспорт антигенов
с последующим развитием иммунной реакции.
Слайд 14Особенности строения кожи и большое число внешних и внутренних факторов,
воздействующих на нее, обусловливают многообразие кожных болезней.
Слайд 15Многие кожные заболевания — результат воздействия биологических факторов: микроскопических грибков,
паразитов, вирусов.
Слайд 16У многих пациентов с кожными болезнями и аллергией выявляется наличие
так называемых «внутренних аллергенов».
К этой категории, например, относятся
глисты и продукты их жизнедеятельности, поскольку это инородные белковые структуры, реально вызывающие аллергию и кожные болезни. Слайд 17Грибковые культуры, например, дрожжевые грибы рода candida, также могут выступать
в роли «внутренних аллергенов».
Поэтому, когда, например, женщина, страдающая
кандидозом, жалуется на сыпь, нельзя рассматривать кожные проявления вне общей клинической картины.Слайд 18Аллергия и кожные заболевания – это не только измененная индивидуальная
реакция организма на те или иные биохимические вещества, но и
имеющаяся неспособность организма к их самостоятельному выведению.Слайд 19Причины всех кожных заболеваний кроются в нарушении работы внутренних органов
– печени, почек, а также лимфатической и иммунной систем, отвечающих
за детоксикацию организма.Слайд 21Дисбиоз кишечника – один из важнейших факторов, провоцирующих возникновение кожных
заболеваний.
При изменении кишечной микрофлоры нарушаются процессы пищеварения и
усвоения питательных веществ. Слайд 23Чудесный симбиоз человека и его микрофлоры
Микробиота кишечника и слизистые оболочки
организма обмениваются
сигнальными молекулами
генетической информацией
являются единой системой!
От здоровья микрофлоры зависит
наше качество жизни и продолжительность жизни! При дисбиозе развиваются:Болезни ЖКТ
Нейродегенеративные болезни
Метаболический синдром
АИЗ
Психические заболевания (аутизм, СХУ)
Бесплодие
Рак
МКБ и ЖКБ
Атопические заболевания
Общий вес микрофлоры 2,5-3,0 кг-это отдельный орган!
Микробита каждого человека индивидуальна-возможна идентификация личности!
Около 1/3 пищи переваривается микробиотой!
Микробиота кишечника образует 20% от общей энергии организма!
Микробиота кишечника дает 90% энергии для клеток эпителия ЖКТ!
Кишечная микрофлора может аккумулировать макро и микроэлементы и сохранять их до 120 дней!
Слайд 24Стрессы справедливо считаются причиной многих заболеваний и кожные заболевания не
являются исключением. Любой стресс – это целый каскад форсированных биохимических
реакций, расшатывающих не только сердечно - сосудистую, но и иммунную систему. Как следствие, - снижение сопротивляемости организма, активизация инфекций, увеличение количества токсинов, выраженная нагрузка на все фильтрующие органы.
Слайд 26Ассоциируется с подростковым возрастом
Традиционно акне ассоциируется с подростковым возрастом, характеризующимся
гормональной перестройкой организма и социальным становлением человека.
Слайд 27Подросток = тинейджер = 13-19 лет
Под воздействием гормона ДГТ (активный
метаболит гормона тестостерона) происходит правильное половое развитие мужчин и женщин
ДГТ
является самым мощным стимулятором синтеза кожного сала. Он вырабатывается в результате преобразования тестостерона ферментом 5α-редуктазойСлайд 28 В индустриально-развитых странах от 79 до 95% тинейджеров испытывают на
себе все «прелести» акне.
Слайд 29Заболеваемость в России
Заболеваемость среди подростков в России до 85%.
16,8
млн молодых людей 14-25 лет–пациенты с акне
Слайд 31Акне вызывает у пациентов психо - эмоциональные расстройства преимущественно депрессивного
характера, тревожность, снижает самооценку и качество жизни, степень эмоционального страдания
и степень тяжести акне не коррелируют.Слайд 32Подростковое акне
У 80% пациентов акне самопроизвольно разрешаются к 18-20 годам,
особенно у лиц мужского пола.
Слайд 34Акне
Во всем мире пациентов с акне не просто стало больше,
а увеличилось количество трудноизлечимых форм.
Слайд 37
Полезные микроорганизмы кишечника
Для питания необходимы сложные углеводы и клетчатка (грубые
волокна), которые не могут быть переварены организмом человека, однако отлично
ферментируются «полезными» представителями бактериальной флоры.Слайд 38Нарушения в питании подростков
Дефицит животных белков
Дефицит ПНЖК
Дефицит витаминов
(С в 70-100%, витаминов группы В и фолиевой кислоты-40-60%, b-каротина-40-60%)
Недостаток
Са, Fe, Se, ZnДефицит пищевых волокон!!!
Слайд 39«Эпидемия» акне у взрослых
Однако теперь, в наши дни, все больше
и больше взрослых людей подвергаются «эпидемии» акне. Косметологи и дерматологи
во всем мире также отмечают о «широком наступлении» акне у взрослых.Слайд 40Статистика
Стойкие (персистирующие) акне, которые наблюдаются примерно у 80% женщин (характерно
начало заболевания в подростковом периоде с постепенным переходом во взрослый
возраст);Акне с поздним началом (манифестация после 25 лет, впервые появляются у 12% женщин и в 3% у мужчин)
Рецидивирующие акне (развиваются у женщин, имевших в анамнезе акне в подростковом возрасте, разрешившиеся в течение нескольких лет).
Слайд 41Старше 25, 41-50 лет
Около 54% женщин и примерно 40% мужчин
в возрасте старше 25 лет всё ещё не могут расстаться
с угревыми прыщами.Акне присутствует у 45% женщин в возрасте 20-29 лет и 12% в возрасте 41-50 лет.
Слайд 43
Не подростковая проблема…
Корни угревой проблемы уходят намного глубже гормональных
перестроек, характерных для “трудного переходного возраста”.
Поэтому акне - не подростковая
проблема. Слайд 44Акне (аcne vulgaris) – хроническое воспалительное заболевание, проявляющееся открытыми или
закрытыми комедонами и воспалительными поражениями кожи в виде папул, пустул,
узлов на фоне генетически обусловленной андрогении.Слайд 45ПАТОГЕНЕЗ АКНЕ
Генетически обусловленный избыток андрогенов/повышенная чувствительность к андрогенам ведет- к
повышению секреции кожного сала в СВФ
-ведет к гиперкератозу (гиперпролиферации эпителия
выводных протоков) и к закрытию протока СВФСнижение альфа-линолевой кислоты в сале усиливает гиперкератоз
что создает благоприятные анаэробные условия для размножения факультативных анаэробов – Cutibacterium acnes (С. acne)
Слайд 46Причины повышения андрогенов в женском организме
В период полового созревания девочек,
когда происходит формирование вторичных половых признаков;
опухолевый процесс (например, поликистоз яичников);
функциональные
нарушения в работе эндокринной системы;проблемы углеводного обмена (при толерантности организма к глюкозе);
функциональные нарушения печени, связанные с выработкой глобулина, недостаток которого не позволяет органам и системам получать женские гормоны в нужном количестве;
прием гормоносодержащих препаратов (тамоксифен).
Проявляется андрогенными дерматозами (угри, себорея, алопеция), нарушением репродуктивной функции.
Слайд 48Строение кожи
Кожа состоит из эпидермиса, дермы и подкожно-жировой
клетчатки (гиподермы).
Эпидермис включает в себя пять слоев эпидермальных клеток (кератиноциты)
Дерма,
или собственно кожа, представляет собой соединительную ткань и состоит из 2-х слоев.Подкожно-жировая клетчатка состоит из пучков соединительной ткани и жировых скоплений, пронизанных кровеносными сосудами и нервными волокнами.
Слайд 49Кератиноциты
Кератиноциты - основной тип клеток
(85 %) эпидермиса. Кератиноциты проходят последовательные стадии дифференцировки от
исходных стволовых клеток до образования роговых (мертвых) чешуек, выполняющих защитную
функцию кожи.Слайд 50Кератинизация
Кератинизация – это последовательный, послойный процесс в эпидермисе, протекающий с
образованием веществ, защищающих кожу от воздействия неблагоприятных внешних факторов.
Слайд 51Линолевая кислота является:
1) Основным регулятором дифференцировки кератиноцитов.
2) От нее зависит
проницаемость кожи и ее защитный барьер.
3) Снижение линолевой кислоты
ведет к повышению продукции провоспалительных цитокинов (IL-1, IL-8, ФНО-альфа), что усиливает гиперкератоз в протоке СВФ. Слайд 52С учетом клинической картины заболевания выделяют:
- комедональные акне;
- папуло-пустулезные акне;
- узловатые акне;
-
конглобатные акне.Слайд 54Патогенез развития Акне
Кератиноциты
Усиление процесса кератинизации в протоке
СВФ, приводящего к закупорке протока (проявляется в зависимости от степени
закупорки: закрытым или открытым камедоном) Сально-волосяной фолликул
Усиление образования кожного сала(увеличение его объема)
Изменение состава сала (снижение в его составе линолевой кислоты)
Что создает благоприятные анаэробные условия для размножения факультативных анаэробов – Cutibacterium acnes (С. acne)
Слайд 55Cutibacterium acne
является представителем нормальной микрофлоры, патогенные свойства C. аcne не
проявляются у здоровых людей.
Слайд 56Плотность колонизации Cutibacterium acnes увеличивается в себорейных зонах, поскольку кожное
сало является питательной средой для них.
Слайд 57Избыточная бактериальная колонизация С.acne играет роль в поддержании патологического процесса.
Слайд 58С.acne стимулируют продукцию IL-1b кератиноцитами и макрофагами и вызывают дополнительную
продукцию провоспалительных цитокинов себоцитами.
Продуцируют АГ, приводящие к образованию ЦИК
Липаза микробов
гидролизует ТГ кожного сала до глицерина, который является питательным субстратом для микробов, и свободных жирных кислот, которые обладают комедогенными свойствами.Колонизация Cutibacterium acnes приводит к повышенной кератинизации в устье волосяного фолликула, а биопленки, создаваемые этими бактериями, дополнительно влияет на формирование гиперкератоза.
Слайд 59Тенденция «взросления» заболевания в настоящее время, его значительное влияние на
психоэмоциональную сферу, социальный статус и общественную адаптацию больных обуславливают актуальность
данной проблемы и дополнительное ее исследование.Слайд 60
Новая концепция патогенеза акне
В результате исследований было установлено, что воспаление
в фолликуле возникает до формирования элементов акне и проявляется значительным
повышением количества CD4 Т-лимфоцитов (Т-хелперы), макрофагов и экспрессии ИЛ-1.Слайд 61При этом повышение маркеров воспаления происходит как в месте последующего
формирования элементов акне, так и в нормальной коже.
Слайд 62Эти находки позволили сделать предположение, что так называемые «невоспалительные элементы»
акне-микрокомедоны и комедоны, на самом деле являются воспалительными.
Слайд 63Научные исследования позволили выявить факторы, предрасполагающие к развитию акне:
Наличие заболевания
в семье (наследственность)
Избыточный вес
Большой рост
Раннее половое развитие
Генетические особенности:
Слайд 64
Генетические особенности
Врожденная гиперплазия надпочечников (дефицит энзима 21-гидроксилаза),
Дефицит ТРФ-бета (трансформирующего ростового
фактора) приводит к нарушению в дифференцировке себоцитов и накоплению липидов.
Дефицит
транскриптационного фактора (Fox01) приводит к усилению сигнала ростовых факторов с активацией ответа на гормоны (андрогенного рецептора), а также увеличение ответа на инсулин).Инсулинорезистентность. Выявлена корреляция тяжести акне с инсулиногенной пищей - молочными продуктами, продуктами с высоким ГИ.
Слайд 65
Ученые дали рекомендации дерматологам
Информировать пациентов о важности диеты: можно
говорить с высокой степенью достоверности о роли 2 пищевых факторов
в развитии акне, это молочные продукты и продукты с высоким гликемическим индексом.Обследовать пациентов на инсулинорезистентность.
Слайд 67Причина акне - рацион питания
«…Существуют убедительные доказательства того, что основной
причиной акне является рацион питания с высоким содержанием сахара и
рафинированных углеводов.Слайд 68В антибиотиках нет необходимости, потому что составление правильного рациона питания
создаст внутреннюю среду, которая НЕ ДОПУСТИТ избыточного роста бактерий.
Слайд 69Наш организм «предпочитает» сложные углеводы, содержащиеся в овощах, сложным углеводам,
содержащимся в зерновых, потому что усваивает он их по-разному.
Слайд 70Растительные углеводы медленно распадаются на отдельные молекулы сахара, с минимальным
вовлечением инсулина, тогда как переваривание зерновых углеводов повышает уровень инсулина
и инсулиноподобного фактора роста (ИФР-1).Слайд 71Повышенный уровень ИФР-1 может привести к увеличению количества мужских гормонов,
из-за которых поры выделяют больше кожного сала — жирного вещества,
в котором задерживаются бактерии, вызывающие акне.Слайд 72ИФР - 1
ИФР-1 также вызывает размножение клеток кожи (кератиноцитов) —
процесс, который тоже связывают с акне.
Вот почему следует избегать большинства
зерновых продуктов, если у вас акне.Данная гипотеза подтверждена исследованиями.
Слайд 73В опубликованном в American Journal of Clinical Nutrition исследовании 2007 г, молодые
люди (в возрасте от 15 до 25 лет), страдающие акне, в
течение 12 недель придерживались низко гликемической диеты, в результате чего, значительно уменьшились проявления акне и чувствительность к инсулину.Подобные результаты были получены в исследовании 2002 г, которое изучало, как хлеб может спровоцировать появление акне.
Слайд 74Отказ от зерновых, сахара (особенно фруктозы), круп, картофеля, кукурузы, риса,
макаронных изделий, обработанных продуктов – поможет значительно уменьшить проявление акне.
Достаточное количество фруктозы содержится во фруктах, поэтому, если вы предрасположены к образованию акне, вам следует уменьшить их употребление. Фруктовых соков следует строго избегать, так как в них очень большое содержание сахара. (Следует отметить, что овощные соки – прекрасная альтернатива, особенно, с содержанием зелени.)»Джозеф Меркола, США, врач, остеопат, натуропат, стаж работы 30 лет.
Слайд 76Мнение специалиста китайской традиционной медицины о причине образования акне:
«Прыщи –показатель
того, что количество токсинов в организме больше, чем организм способен
вывести, приходится временно складировать избытки под кожей. Функциональное состояние органов, отвечающих за вывод токсинов (печени и почек) ослаблено, способность к транспортировке отходов невелика. Ослаблен контроль поступающих в организм продуктов, человек потребляет слишком много мусора и токсинов».Слайд 77В настоящее время также известно, что ключевую роль в возникновении
себореи открытых участков кожи и ВЧГ играет дрожжевой грибок Pityrosporum
ovale. Тяжесть заболевания находится в прямой зависимости от количества этого грибка.Слайд 78При себорее захватывается кожа головы, лица, заушных складок, шеи. Особенно
подвержены себорее следующие участки: ВЧГ, нос, носогубные складки, лоб, щеки,
подмышки, пупок, бедрено-мошоночные складки, пупок, грудь, спина.Слайд 79Себорея
Различают:
сухую,
жирную,
густую,
жидкую
смешанную себорею:
- на одних участках
кожи симптомы сухой,
- на других-симптомы жирной себореи.
Жирная себорея предрасполагает
к образованию угревой сыпи.Слайд 80
Лекарственные грибы, которые подавляют развитие Pityrosporum orbiculare в организме
Мухомор
Веселка
Трутовик
лиственничный
Дождевик
Кордицепс
Слайд 81
Базовая фунготерапия при кожных заболеваниях
1 этап –
необходимо «убрать» глистные инвазии и дисбактериоз кишечника:
Лисички по 2 кап.
2 раза в день.Трутовик по 2 кап. 2 раза в день.
Курс – 1 месяц.
Слайд 82
Базовая фунготерапия при кожных заболеваниях
2 этап – улучшить состояние
сосудов и капиляров, питающих кожу и очисть лимфу:
Рейши по 2
кап. 2 раза в день.Дождевик по 2 кап. 2 раза в день.
Курс – 1 месяц.
Слайд 83Базовая фунготерапия при кожных заболеваниях
3 этап – непосредственно
насытить организм лучшими микроэлементами, минералами, хитином и витаминами, входящими в
состав этих грибов:Весёлка по 2 кап. 2 раза в день.
Болетус по 2 кап. 2 раза в день.
Курс – 1 месяц.
Слайд 84Фунготерапия при угревой болезни
Дополнительно к базовой терапии Мейтаке
нормализация гормонального фона,
улучшение
функции печени
уменьшение инсулинорезистентности
нормализация углеводного обмена
Слайд 85Маски
Для качественного косметического ухода за кожей лица –
маски из гриба Весёлки и Мейтаке.
Слайд 86Маска Веселка
Маска, омолаживающая для лица и декольте
с активными веществами гриба «Веселка» - ежедневное применение маски в
течении недели устраняет раздражение и шелушение кожи. Полисахариды гриба ВЕСЕЛКА смягчают и тонизируют кожу. Улучшают кровоснабжение кожи, обеспечивая питанием через капилляры, не вызывает аллергии.Слайд 87Маска Мейтаке
Маска, омолаживающая для лица
и декольте с керамидами гриба «Мейтаке», обеспечивающая наличие достаточного количества
керамидов в эпидермисе кожи. Керамиды грибов легко впитываются и усиливают регенирацию молодых клеток. В Японской медицине МЕЙТАКЕ называют «Грибом молодости», вытяжку из него применяли для сохранения жизненной энергии и красоты лица.Слайд 88Противовоспалительный эффект
Ежедневное использование кремов Шиитаке и Весёлка даёт
противовоспалительный,
антибактериальный,
стойкий омолаживающий эффекты.
Слайд 89Пчелиная огневка
Крем из пчелиной огневки разгладит кожу, убирая
рубцы и шрамы. Подтянет и улучшит тургор ткани.
Слайд 90Тоник
Использование тоника из концентрата серебряной воды обезвредит верхние
слои кожи и поможет избежать различных высыпаний, связанных с инфицированием
кожи.Слайд 91Крем Рейши
Принимает активное участие в лечении акне
Очищает кожные покровы
от прыщей, комедонов
Создает кислую среду, губительную для микроорганизмов
Слайд 92Грибная косметика от Ирины Филиповой
Грибная косметика от
Ирины Филипповой – секрет Вашего здоровья и красоты в любом
возрасте!Тонизирующий и омолаживающий эффект вытяжек из высших грибов был известен еще тысячи лет назад. Современная грибная косметика приобрела популярность, благодаря, грибным полисахаридам – активным веществам, отвечающим за работу иммунной системы, и что самое ценное в косметологии – за восстановление клеток кожи.